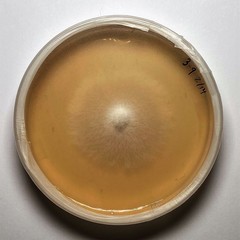
Cladosporium ramotenellum
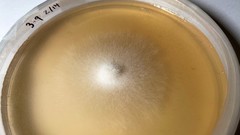
Cladosporium ramotenellum

Cladosporium ramotenellum: taxon details and analytics
- Domain
- Kingdom
- Fungi
- Phylum
- Ascomycota
- Class
- Dothideomycetes
- Order
- Capnodiales
- Family
- Cladosporiaceae
- Genus
- Cladosporium
- Species
- Cladosporium ramotenellum
- Scientific Name
- Cladosporium ramotenellum
Images from inaturalist.org observations:
We recommend you sign up for this excellent, free service.
Parent Taxon
Sibling Taxa
- Cladosporium aecidiicola
- Cladosporium allicinum
- Cladosporium allii
- Cladosporium alneum
- Cladosporium arthropodii
- Cladosporium atriellum
- Cladosporium auriculae
- Cladosporium austrohemisphaericum
- Cladosporium brunneoatrum
- Cladosporium butyri
- Cladosporium chamaeropis
- Cladosporium citri
- Cladosporium cladosporioides
- Cladosporium colocasiae
- Cladosporium crousii
- Cladosporium cucumerinum
- Cladosporium cycadicola
- Cladosporium echinulatum
- Cladosporium epichloes
- Cladosporium eriobotryae
- Cladosporium fasciculare
- Cladosporium fraxinicola
- Cladosporium herbarum
- Cladosporium hillianum
- Cladosporium hypophyllum
- Cladosporium iridis
- Cladosporium lacroixii
- Cladosporium licheniphilum
- Cladosporium lophodermii
- Cladosporium macrocarpum
- Cladosporium maculans
- Cladosporium magnusianum
- Cladosporium nigrellum
- Cladosporium oncobae
- Cladosporium oxysporum
- Cladosporium perangustum
- Cladosporium pericarpium
- Cladosporium phlei
- Cladosporium phyllophilum
- Cladosporium polygonati
- Cladosporium pseudiridis
- Cladosporium ramotenellum
- Cladosporium sinuosum
- Cladosporium sphaerospermum
- Cladosporium spongiosum
- Cladosporium syringae
- Cladosporium tenuissimum
- Cladosporium trillii
- Cladosporium trilliicola
- Cladosporium typhae
- Cladosporium uredinicola
- Cladosporium variabile
- Cladosporium vicinum
- Cladosporium vincicola
- Cladosporium xylophilum
- Davidiella carinthiaca